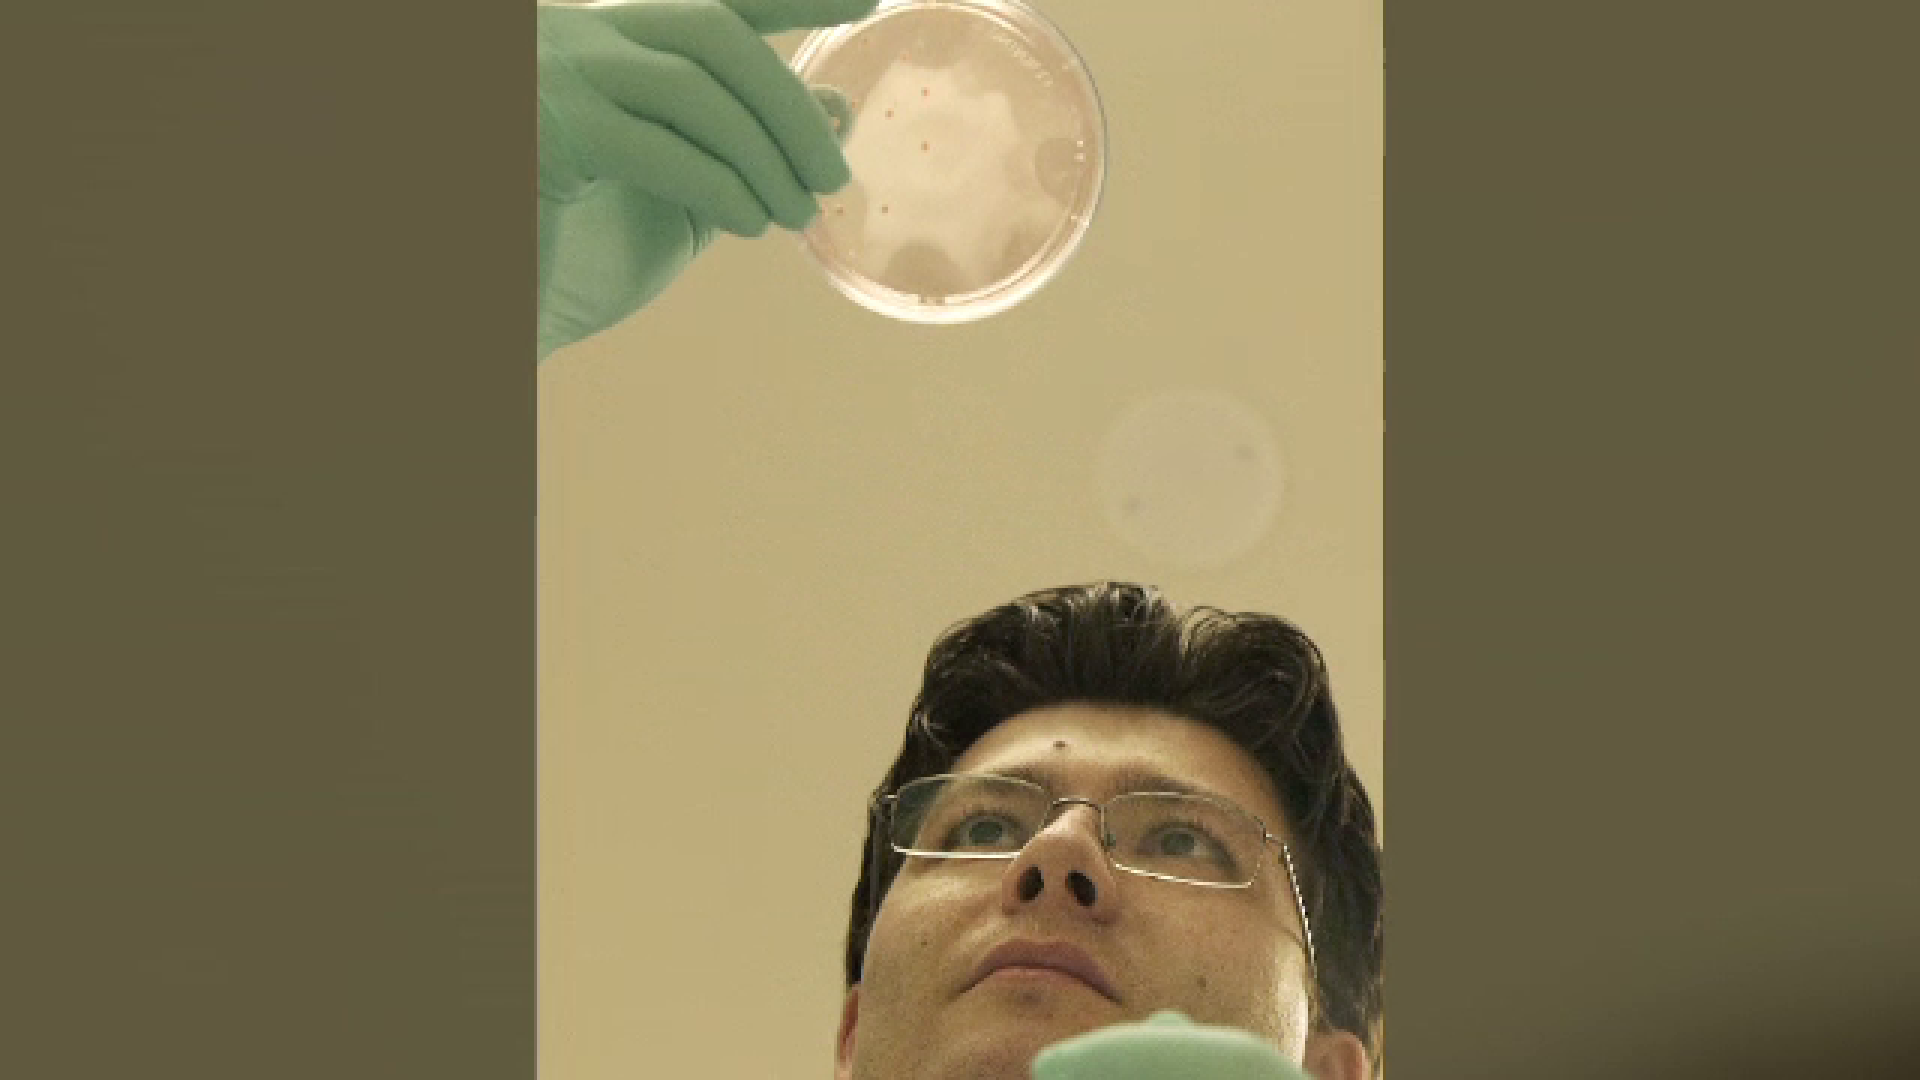
Sergiu Pașca

Născut la Aiud, caută leacul pentru autism la Stanford.Cercetătorul care obține porțiuni de creier din simple celule de piele
Să "românești" în biomedicina viitorului înseamnă să ai medicamente care să amelioreze sau chiar să vindece autismul și alte afecțiuni similare.
La asta lucrează un român, cercetător emerit la Stanford, una dintre cele mai prestigioase instituții de învățământ din lume.
Are propriul laborator în care a obținut o performanță uriașă: poate obține porțiuni de creier atificial, din simple celule de piele. De aici până la substanțe care să îmbunătățească performanța neuronilor mai este mult, însă descoperirea romanului deja revoluționează metodele de studiu ale creierului.
Ce ați spune dacă un om de știință v-ar lua într-o zi câteva celule de piele de pe mâna, ca după câteva luni să va puteți vedea propriul creier, în miniatură, obținut într-un recipient medical? De ce am avea nevoie de o asemenea descoperire? Răspunsul îl găsim în acest laborator de neuroștiințe de la celebra Universitate Stanford, din America.
Sergiu Pașca, doctor în neuroștiințe la Stanford: "La momentul actual putem recrea în laborator, de la orice individ, o bucățică, de exemplu, de creier, sau putem recrea diferite regiuni ale creierului și apoi le putem conecta în laborator, vedem cum vorbesc unele cu altele."

Sergiu Pașca are 36 de ani și este unul dintre cei mai tineri profesori-cercetători de la Stanford. Deține propriul laborator la Stanford și, după numai 3 ani de activitate, a făcut deja o descoperire care poate schimba viitorul omenirii. Are o misiune clară - să descifreze tainele autismului. Primește fonduri generoase în fiecare an de la stat și universitate, iar americanii au crezut de la început în descoperirera lui.
Sergiu Pașca: “Oportunitatea acestor celule este de a vedea ce nu merge bine în creier. Am reușit să obținem o porțiune a creierului care este stratul de deasupra, cortexul cerebral, unde funcția cognitiva e localizată, are mai multe straturi, 6 straturi, are neuroni inhibitori. Avem ceva rezultate la forme de autism destul de rare, dar care ne spun ce procese ar putea fi alterate."
Simte și vede că în demersul său e susținut în America din toate părțile. Are o echipa formată din tineri, studenți eminenți din toată lumea și e mândru că primele rezultate obținute cu acești cercetători dau omenirii speranțe uriașe.
Sergiu Pașca, cercetător la Stanford: “De exemplu, dacă iei neuroni de la pacienți cu autism și de la cei fără și îi depolarizezi, îi stimulezi electric la cei fără, se deschid dendritele. Și să identificăm modalități de a împiedică asta, să punem substanțe chimice. De a restaura această anomalie și să prevenim. În principiu, da, avem substanțe care să deverseze. Nu sunt pregătite să meargă în clinică, așa se începe.”
Reporter: “Am putea vorbi de o pilulă minune pentru autism?”
Sergiu Pașca: “Asta e în ultimă instanță speranța tuturor, că vom avea substanțe chimice capabile de a îmbunătăți, dacă nu reversa anumite forme de autism. E posibil că anumite forme să fie reversibile!”
Până la medicamente care să amelioreze autismul mai este mult, dar romanul Sergiu Pașca e convins că va reuși, iar medicina viitoarelor decenii va avea o componentă importantă în tratarea autismului.
Sergiu Pașca: "Mergem pe medicina individualizată, în care pentru fiecare pacient încercăm să identificăm o terapie."
S-a întors în timp, pentru a ajunge în viitor, atunci când a gândit metoda ingenioasă de a obține celule nervoase, pe lamela de la microscop.
Sergiu Pașca: “Reușim să le împingem înapoi în timp, să arate ca și celulele stem, celulele pluripotențiale, din care practic noi ne dezvoltăm. Avantajul? Celulele stem se pot transforma în orice celulă. Și noi le ghidăm pentru a se tranforma în neuroni, astrocite sau alte celule ale creierului."
S-a născut la Aiud unde a și devenit cetățean de onoare al orașului. Și-a început cercetarea în autism încă de când era acasă, în România, unde l-au impresionat copiii și afecțiunile lor.
Sergiu Pașca: "Am început să studiez autismul pe când eram în facultate, la Cluj. Părintii unuia dintre pacientii cu care țin legătura și astăzi veneau și mă îmbratișau, chiar vrei să studiezi, în sfârșit cineva vrea să studieze și boala asta, că suntem disperați. Și evenimentele astea au avut o puternică influență în viață mea."
Atunci îl cunoștea pe Dudu, un copilaș din Bistrița Năsăud, diagnosticat cu autism. Modul cum a evoluat Dudu și alți copii pe care i-a văzut în România l-au mânat să-și intensifice cercetarea peste Ocean.
Sergiu Pașca: "Unul din primii subiecți pe care i-am avut în România la ora actuală este un compozitor de pian foarte realizat, în Bistrița. Din păcate în România, comunitatea este foarte dezorganziata și dezinformată. Este o foarte mare contribuție genetică, la dezvoltarea autismului."
A ținut legătura cu mama lui Dudu, îi vizitează și se văd ori de câte ori vine în România. Dudu i-a făcut și un desen, care a stat la baza logo-ului de la laboratorul de la Stanford.
Sergiu Pașca, doctor în neuroștiințe la Stanford: "Este într-un fel ultima frontieră, creierul și bolile creierului. După cum știți nu există niciun tratament pentru bolile psihiatrice, care să fie definitiv, majoritatea tratamentelor pe care le avem sunt parțiale. Nu există un test de laborator să îți spună că ai autism. Scopul este ca încetul cu încetul să găsim metode de a diagnostica mai bine formele de autism, dar și subforme de autism. Autismul nu este o singură boală, e un grup de boli."

Universitatea Stanford încurajează cercetarea în biomedicină. Are un centru special amenajat, unde medicii intră în contact cu direct inginerii, pentru a crea tehnologii moderne.
Romanul face reprogramare celulară într-unul din cele mai bune locuri din lume. La Stanford, printre genii, se simte în elementul sau. Cercetarea lui Sergiu Pașca nu se rezumă doar la autism, ci ar putea avea aplicații uimitoare și în modul în care e studiată îmbătrânirea celulei umane.
Sergiu Pașca: "Aceste culturi pe care le dezvoltăm pot dura mult în timp, până la 850 de zile. Și ne-am uitat să vedem cum se maturează. Și timpul e foarte bine controlat, înaintau în vârstă, am văzut că după 9 luni, aceste celule capătă trăsăturile unui țesut din creierul postnatal, au un anumit ceas aceste celule. Si exact această maturare ar putea să arate procesele."
E căsătorit cu o româncă, fostă colegă de facultate, care la rândul ei este un important cercetător în laborator, dar și medic la Spitalul din Stanford. Au împreună un băiețel de 4 ani, pe care îl cresc singuri în marele centru universitar, fără bonă sau rude. I-au făcut cunoștință deja cu munca de laborator.
Sergiu Pașca: "Noi am fost în același an la Medicină la Cluj, acasă vorbim exclusiv românește. Nu știu dacă pe copil îl fac cercetător, toți copiii sunt mici cercetători, sunt foarte curioși, întreabă în permanentă. Are un mic laborator pe balcon de câteva zile și singur își amestecă soluții, dar se face ce vrea el."
Un român revoluționează medicina mondială și se avântă într-un domeniu deloc ușor, de care mulți se feresc. Are indrazneala să se teleporteze într-un viitor în care autismul ar putea avea leac. Nu face promisiuni, în schimb face tot ce poate că să afle tainele celulelor nervoase. Sergiu Pașca lucrează la o lume în care părinții copiilor cu afecțiuni ale creierului au și soluții, nu doar speranțe.
Etichete: 1 decembrie, autism, cercetare, medicina,
Dată publicare:
























